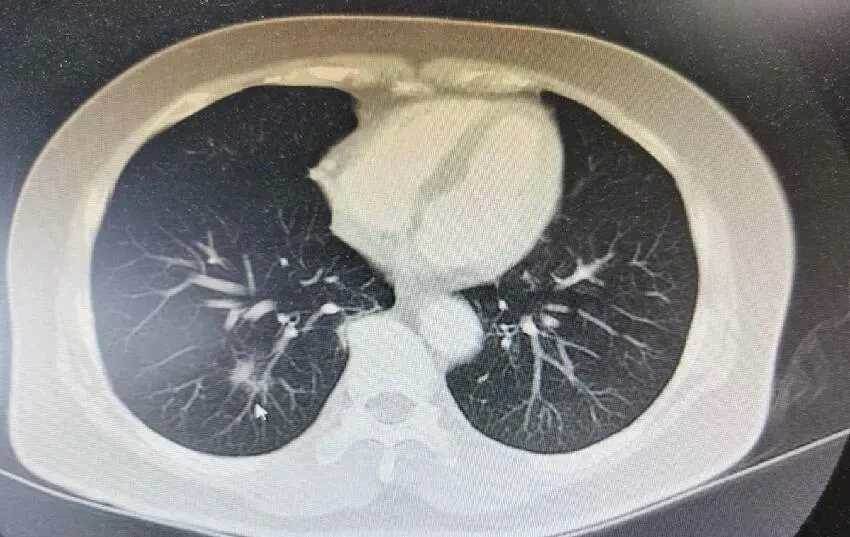

肺部有癌「雙腳先知」若同時出現「4個現象」或癌癥已到了中晚期
ADVERTISEMENT
王阿姨今年57歲,身體一直比較健康,從來沒有患過重大疾病。
她平時特別喜歡跳廣場舞,突然有一天跳廣場舞的時候發現雙腳比較疼痛。
回到家後,她趕忙脫掉鞋子,發現雙腳有些浮腫。
開始她也沒有重視,以為自己最近活動量比較大造成的。

接下來半個月王阿姨都沒有去跳廣場舞,一直待在家中休養。
卻發現雙腳浮腫不但沒有改善,反而疼痛癥狀更加嚴重,甚至走路都受到了影響。
最近半個月沒有運動,雙腳並沒有得到改善。
引起了她的擔心,隨後趕緊來到醫院進行檢查。
通過全面檢查醫生告知王阿姨:她得了肺癌了。
聽到這個消息,猶如晴天霹靂,她一時間無法接受。
ADVERTISEMENT

萬幸的是王阿姨發現的比較早,現在是肺癌早期。
積極配合醫生的治療,痊癒的機率還是比較高的。
為什麼突然就肺癌晚期了?肺部有癌,雙腳先知?
若同時出現4個現象,或癌癥已到了中晚期。肺部有癌,雙腳先知?
肺癌是公認的發病率和死亡率最高的一種癌癥。
肺癌的轉移速度非常快,治療起來比較困難,生存率也相對比較低。
絕大多數的癌癥在早期是很難被發現的,等到被發現多數是中晚期,療愈的可能性也很低。

經過對臨床數據分析顯示:癌癥在來臨之前身體都會有不同反應。
肺癌作為癌癥發病率最高的癌癥,通常雙腳出現癥狀最早。
王阿姨雖然被檢查出了癌癥,但是她確實是癌癥患者中很幸運的一位。
肺癌早期能夠療愈的機率是比較高的,很多患者療愈後,生命通常可以延續5-10年,甚至更久。
當身體出現不適的時候,一定要引起重視。
及時去醫院做全面檢查,能夠有效的避免疾病的發生。

警惕4個現象,或癌癥已到中晚期
1、雙腳疼痛
如果出現雙腳疼痛,在休息後仍然沒有得到明顯好轉,這個時候要警惕肺癌的發生。
肺癌患者之所以會出現雙腳疼痛,這是因為肺癌,通過血液和淋巴系統進行了擴散。
引起局部疼痛和不適,通常雙腳出現疼痛是肺癌的早期癥狀,如果能夠及時發現,早期肺癌是可以療愈的。
如果雙腳疼痛不能夠引起重視,等到癌細胞擴散到全身各處,會導致身體的各個神經受到壓迫,造成全身疼痛。
這個時候可能已經發展成肺癌晚期了,再想療愈非常困難。
部分人對痛感沒有那麼明顯,覺得雙腳疼痛,可能是走路走多了,不太會引起重視。
建議大家這個時候可以選擇去醫院拍一下CT照片,檢查一下肺部是否有問題,早發現早治療,以免延誤病情。

文章未完,點擊下一頁繼續
文章未完,點擊下一頁繼續



















